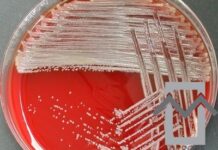
Brevundimonas vesicularis sepsis brevundimonas

The SEHA International Nursing, Midwifery & Allied Health Conference (SINMAC 11) is coming to Abu Dhabi from November 7–9, 2025, at the beautiful Fairmont Bab Al Bahr.
This year’s theme — “Caring Beyond Borders: Empowering Communities Through Nursing Excellence” — highlights how healthcare professionals can make an impact that reaches far beyond hospital walls.
A Space for Connection and Growth
SINMAC has grown into one of the region’s most anticipated healthcare events, bringing together nurses, midwives, and allied health professionals from around the world. It’s a space where ideas are shared, experiences exchanged, and innovation takes shape.
Attendees can expect inspiring keynote talks, hands-on workshops, and sessions led by global experts covering leadership, community care, clinical practice, and professional well-being. Whether you’re a seasoned practitioner or just starting your career, SINMAC offers something valuable for everyone.
Why You Should Go
Beyond the knowledge and skill-building, what makes SINMAC special is the sense of community it fosters. You’ll meet people who share your passion for patient care and who are eager to collaborate and learn.
It’s a chance to recharge, reconnect, and reimagine what nursing and allied health can look like in a rapidly changing world.
And if you have a project, study, or innovative idea — this is the perfect stage to share your work and inspire others.
Be Part of It
If you’re committed to advancing healthcare, don’t miss this year’s SINMAC conference.
Join colleagues from across the region and beyond for three days of learning, inspiration, and community.
Visit www.sinmac.ae for details on registration and abstract submissions.
Early-bird registration is now open — and spots fill up fast!